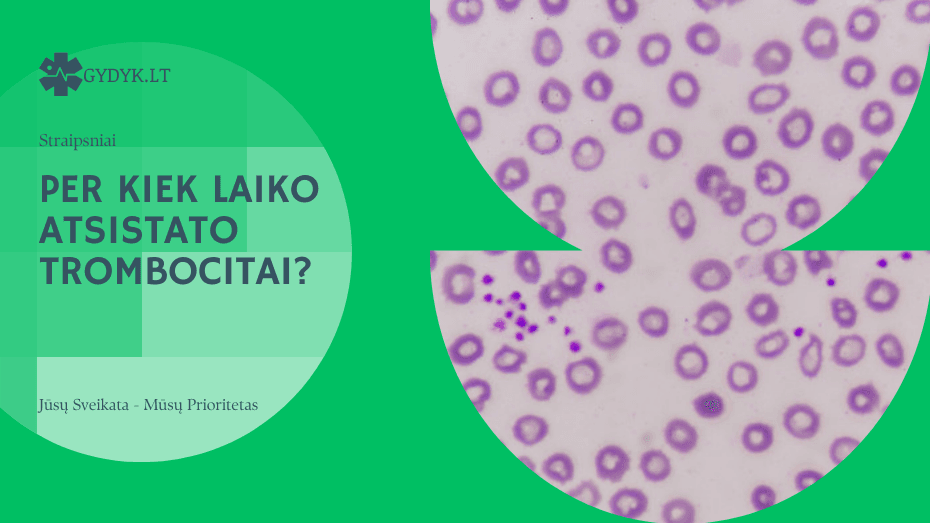
Per kiek laiko atsistato trombocitai? Per kiek laiko atsistato trombocitai

Per kiek laiko sugija ausies būgnelis?
2025 2 sausio
Ausies būgnelio (membrana tympani) pažeidimas gali įvykti dėl įvairių...
Kiek laiko galioja vairuotojo medicininė pažyma?
2025 2 sausio
Vairuotojo medicininės pažymos galiojimo trukmė Lietuvoje priklauso nuo...
Per kiek laiko atsistato trombocitai?
2025 2 sausio
Trombocitai, dar vadinami kraujo plokštelėmis, yra svarbūs kraujo...
Per kiek laiko praeina saulės smūgis?
2024 31 gruodžio
Saulės smūgis yra būklė, kai organizmas perkaitęs nuo intensyvios saulės...
Per kiek laiko pradeda veikti No-Spa?
2024 31 gruodžio
No-Spa (drotaverinas) yra dažnai naudojamas spazmolitinis vaistas, kuris...
Per kiek laiko sugyja skrandžio opa?
2024 31 gruodžio
Skrandžio opa yra gleivinės pažeidimas, dažnai sukeltas per didelės...
Per kiek laiko praeina bitės įgėlimas?
2024 31 gruodžio
Bitės įgėlimas gali sukelti skausmą, patinimą ir paraudimą, tačiau...
Per kiek laiko miršta danties nervas?
2024 31 gruodžio
Danties nervo (pulpės) mirtis, dar vadinama nekroze, yra procesas, kuris gali...
Kiek laiko trunka cistos operacija?
2024 31 gruodžio
Cistos operacijos trukmė priklauso nuo cistos vietos, dydžio, sudėtingumo ir...
Ar galima pastoti išgėrus Escapelle?
2024 31 gruodžio
Escapelle yra skubiosios kontracepcijos tabletė, kuri naudojama po nesaugaus...